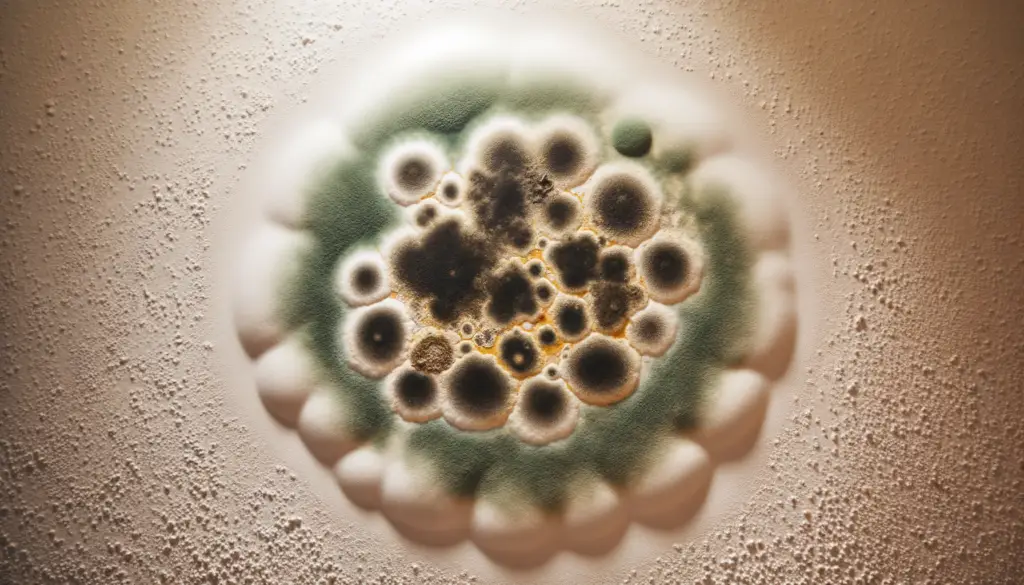
A spot of Cieling mold florida home

Living in Florida, it’s not uncommon to encounter roof mold due to the humid and warm climate. Not only is roof mold unsightly, but it can also pose health risks to you and your loved ones. In this article, we will guide you on how to identify roof mold in your Florida home, the tools and materials needed for removal, a step-by-step guide to removing roof mold, and how to prevent it from returning.
Identifying Roof Mold in Your Florida Home
The first step in addressing roof mold is to identify its presence. Look for dark, greenish, or black patches on your roof, particularly in areas that receive less sunlight or where water accumulates. You may also notice a musty odor coming from your attic or ceiling, indicating the presence of mold. If you suspect mold on your roof, it’s essential to take action promptly to prevent it from spreading and causing further damage.
Tools and Materials Needed for Removal
Before tackling roof mold removal, gather the necessary tools and materials. You will need a ladder to access your roof safely, a garden hose with a spray nozzle or pressure washer, a scrub brush or sponge, a solution of water and mild detergent or bleach, safety goggles, gloves, and a facemask. Additionally, consider using a mold inhibitor or preventive spray to discourage mold regrowth after removal.
Step-by-Step Guide to Removing Roof Mold
Preventing Roof Mold from Returning
To prevent roof mold from returning, ensure your attic and roof are well-ventilated to reduce moisture buildup. Trim overhanging tree branches to allow sunlight to reach your roof and discourage mold growth. Regularly inspect your roof for signs of mold or water damage and address any issues promptly. Consider applying a mold-resistant coating to your roof or using mold inhibitors to protect against future mold growth. By taking preventive measures, you can keep your Florida home mold-free and maintain a healthy living environment for you and your family. By following these steps and staying vigilant in maintaining your roof, you can effectively remove roof mold from your Florida home and prevent its return. Remember that mold removal can be a challenging task, and it’s essential to prioritize safety throughout the process. If you’re unsure about tackling roof mold on your own, don’t hesitate to seek professional help. With proper care and maintenance, you can keep your home mold-free and enjoy a safe and healthy living space in the Sunshine State.
You might be interested in learning more about mold prevention and removal techniques by checking out the article on Mold on Wikipedia. Additionally, if you want to delve deeper into the climate of Florida and how it can affect your home, you can read about it in the Climate of Florida article. Staying informed about these topics can help you better understand and combat roof mold in your Florida home.
[/et_pb_text][/et_pb_column][/et_pb_row][/et_pb_section]

